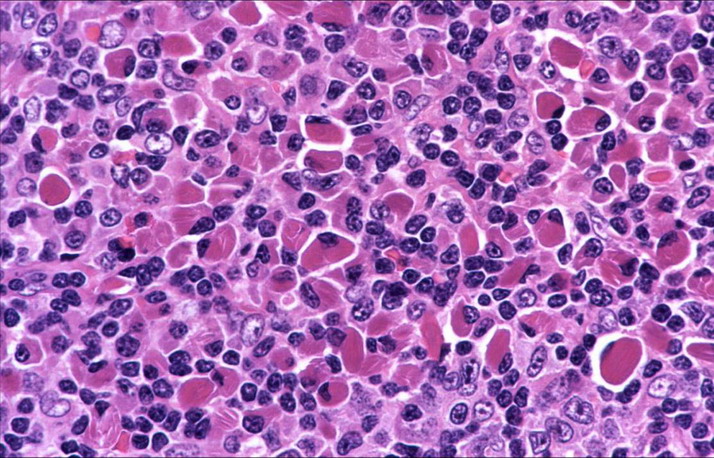
淋巴母细胞瘤

淋巴母细胞

t淋巴母细胞白血病淋巴瘤talllbl病例分享与解析
图片尺寸578x433
淋巴细胞图片_百度百科
图片尺寸459x640
傻傻分不清的淋巴细胞
图片尺寸1000x750
p>淋巴细胞(lymphocyte)是白细胞的一种,是体积最小的白细胞.
图片尺寸649x434
中间的淋巴细胞是成熟的吗
图片尺寸3264x2448
淋巴母细胞瘤
图片尺寸757x500
淋巴细胞篇(形态)787878
图片尺寸1080x1439
淋巴母细胞瘤
图片尺寸700x476
p>淋巴细胞(lymphocyte)是白细胞的一种,是体积最小的白细胞.
图片尺寸575x379
1急性淋巴母细胞样白血病
图片尺寸1152x849
淋巴母细胞,一种不成熟的白细胞
图片尺寸1200x800
急性淋巴细胞白血病
图片尺寸716x540
Ⅱ型免疫母细胞性淋巴腺病
图片尺寸500x375
淋巴母细胞瘤
图片尺寸714x458
各种淋巴细胞及其它细胞
图片尺寸2000x2666
淋巴细胞b细胞
图片尺寸1500x1500
t2(174xcem.t2) 人淋巴母细胞【通过str鉴定】
图片尺寸1280x958
淋巴细胞
图片尺寸1080x810
淋巴结的正常组织学_细胞
图片尺寸665x569
抗癌成功的体会: 首先,和大家分享有关t淋巴母细胞淋巴瘤的疾病知识
图片尺寸640x631